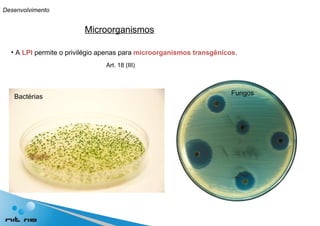
Microorganismos A  LPI  permite o privilégio apenas para  microorganismos   transgênicos . Art. 18 (III) Bactérias Fungos Desenvolvimento

O documento discute a relação entre propriedade intelectual e genômica, destacando a evolução da biotecnologia e a desenvolvimento de patentes relacionadas a organismos geneticamente modificados. A pesquisa enfatiza a importância da legislação brasileira sobre patentes e os avanços na biotecnologia, abordando temas como a modificação genética, o uso sustentável da biodiversidade e o potencial do Brasil como líder em biotecnologia. A conclusão ressalta a necessidade de capacitação e maior valorização das inovações científicas no contexto econômico do país.

![Muito obrigada! Vanessa Amaral Leonardo Email: [email_address] Rua Lauro Miller, 455 / Sl. 305. Botafogo Rio de Janeiro (RJ). Brasil. CEP: 22290-180 Tel: + 55 (21) 21417277 Fax: + 55 (21) 21417426 www.nitrio.org.br](https://image.slidesharecdn.com/apresentaovanessa-100621122155-phpapp01/85/Propriedade-Intelectual-em-Genomica-42-320.jpg)